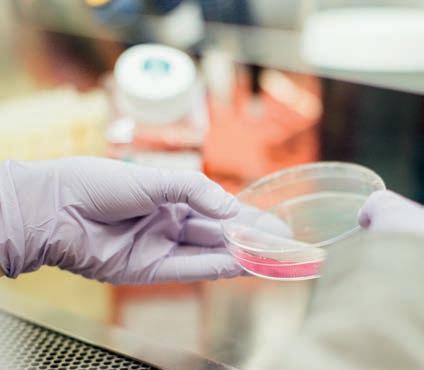

NATURALNE SKUTECZNE OPATENTOWANE*



Suplementy:
Formuła opracowana wspólnie z Badawczym Instytutem Dr Ratha
Dr. Rath Health Programs B.V.

Postbus 657 | 6400 AR Heerlen | Holandia
Faks: 0031 - 457 111 119 info@rath-programs.com www.dr-rath.com

* A merykański Urząd Patentowy uznał określone kompozycje mikroelementów, opracowane w naszym instytucie badawczym. Po raz pierwszy oficjalnie potwierdzono biologiczną skuteczność pewnych zestawów mikroelementów na systemy komórkowe organizmu ludzkiego. Aby odpowiednie patenty mogły zostać przyznane, konieczne było naukowe udowodnienie skuteczności każdego pojedynczego składnika. Uznanie naszych badań przez amerykańską agencję rządową ma wpływ na całą dziedzinę opartych na nauce naturalnych terapii.

SPIS TREŚCI
WITAMY W DR. RATH HEALTH PROGRAMS
DR RATH – TWÓRCA MEDYCYNY KOMÓRKOWEJ
ZDROWIE ZACZYNA SIĘ NA POZIOMIE KOMÓRKOWYM
NAUKOWO PRZEBADANE PRODUKTY ZDROWOTNE
NATURALNIE OPATENTOWANE: NASZE FORMUŁY
ZNACZENIE SYNERGII MIKROSKŁADNIKÓW ODŻYWCZYCH
WITAMINA C, GŁÓWNY SKŁADNIK PRODUKTÓW DR RATHA
JAKOŚĆ PROGRAMÓW ZDROWIA KOMÓRKOWEGO DR RATHA
WAŻNE WSKAZÓWKI DOTYCZĄCE SKŁADNIKÓW I DODATKÓW
SKŁADNIKÓW ODŻYWCZYCH?
ZADANIA I CELE NASZEJ PRACY
PROJEKT OGRÓDKÓW SZKOLNYCH W AFRYCE ABONAMENT KOMÓRKOWYCH
© Dr. Rath Health Programs B.V. 01
ZALECENIA DOTYCZĄCE SUPLEMENTACJI ŻYWNOŚĆ – ODPOWIEDNIE ŹRÓDŁO KOMÓRKOWYCH
SKŁADNIKÓW ODŻYWCZYCH PROGRAM AFILIACYJNY WIĘCEJ PYTAŃ? 02 03 04 06 10 12 13 14 15 16 17 18 20 22 24 25
SERDECZNIE WITAMY W DR. RATH HEALTH PROGRAMS
Niniejsza broszura informuje o Programach Zdrowia Komórkowego dr Ratha, które oferują różnorodne, innowacyjne i zorientowane na przyczyny zestawy mikroelementów do uzupełniania dziennej diety. Nasza firma, Dr. Rath Health Programs, różni się od innych firm produkujących suplementy diety tym, że jest w pełni własnością fundacji non-profit. Z wypracowanych zysków finansujemy przede wszystkim badania oparte na naukowych podstawach naturalnych metod profilaktyki zdrowia oraz rozpowszechnianie wyników tych badań na całym świecie. Nasze suplementy diety są opracowywane zgodnie z najnowszymi odkryciami naukowymi i co więcej – są opatentowane. Jest to unikalne w skali światowej!
Mamy nadzieję, że udało nam się Ciebie przekonać o wyjątkowości naszych Programów Zdrowia Komórkowego. Kupując te unikalne produkty, pozwalasz nam doradzać i wspierać Ciebie w jednej z najważniejszych dziedzin życia – w dziedzinie zdrowia i dobrej kondycji fizycznej.
Zalecamy, abyś skonsultował się z terapeutą lub doradcą zdrowia, w celu zadbania o swoje osobiste problemy zdrowotne. Możesz skorzystać z bezpłatnego doradztwa w naszej firmie i uzyskać indywidualną poradę dotyczącą Twojego indywidualnego celu zdrowotnego – to nic nie kosztuje, poza odrobiną czasu!
Służymy Ci radą od poniedziałku do piątku w godzinach od 08:30 do 17:00.
Bezpłatny Serwis Klienta i Zamówienia*: 00800 – 11 24 639
Czekamy na Twój telefon.
Zespół Dr. Rath Health Programs
* nr
dla dzwoniących z
02 © Dr. Rath Health Programs B.V.
bezpłatny
telefonu stacjonarnego. Dla dzwoniących z telefonu komórkowego, opłata zgodna z taryfą operatora.
DR RATH – TWÓRCA MEDYCYNY KOMÓRKOWEJ
Dr. Rath Health Programs B.V. jest jedną z niewielu firm w sektorze badań nad mikroelementami i opracowanymi suplementami diety, która nosi nazwisko naukowca. I to nie bez powodu. Dr Rath odkrył, że zdrowie i choroba rozstrzygają się na poziomie miliardów komórek organizmu. Tak więc powszechnie występujące choroby, takie jak zawały serca, udary mózgu czy nowotwory, są wynikiem chronicznego braku witamin, minerałów, aminokwasów i innych mikroelementów – zwanych też u dr Ratha komórkowymi substancjami odżywczymi – w milionach komórek. Jeśli komórki są zaopatrywane w wystarczającą ilość mikroelementów, to można zapobiegać chorobom. Dr Rath ukuł dla tego spostrzeżenia termin „Medycyna Komórkowa”.
Dr Rath był współpracownikiem i przyjacielem dwukrotnego laureata Nagrody Nobla, dr Linusa Paulinga. Razem opublikowali kilka przełomowych prac badawczych na temat roli mikroskładników odżywczych w zapobieganiu chorobom układu krążenia. Po śmierci Paulinga w 1994 roku, dr Rath i jego zespół naukowców systematycznie rozwijali badania nad witaminami w założonym przez niego instytucie badawczym. Przełomowe odkrycia dr Ratha w sektorze zdrowia naturalnego stworzyły również podstawy dla powstania nowatorskich naturalnych produktów, które są dostępne na całym świecie jako Programy Zdrowia Komórkowego.

© Dr. Rath Health Programs B.V. 0 3
Fotograf: Evert-Jan Daniels
ZDROWIE ZACZYNA SIĘ NA POZIOMIE KOMÓRKOWYM
Jeśli wiesz, jak działa Twój organizm, to będziesz też wiedział, dlaczego czasem czujesz się bardzo dobrze, a czasem gorzej. Jak to się dzieje, że jesteś zdrowy i dlaczego możesz zachorować.
Twoje zdrowie zależy od najmniejszej
jednostki Twojego organizmu – od komórki. Przyjrzyjmy się temu z bliska.
• Nasz organizm składa się z trylionów komórek, najmniejszych żywych jednostek w naszym ciele. Ich działanie decyduje o tym, jak dobrze czy jak źle się czujemy.
• Jeśli komórka nie funkcjonuje, organ – a w konsekwencji organizm – nie może funkcjonować prawidłowo. W takich przypadkach, mówiąc najprościej, komórka jest niedożywiona –brakuje jej składników odżywczych.
• Zdrowie i choroba są rozstrzygane na poziomie komórkowym: Jeśli komórka ma niedobory, to przestaje funkcjonować: częściowo lub całkowicie, zaczyna chorować i/lub umiera.
Wspólną cechą wszystkich komórek jest to, że muszą być zaopatrywane w odpowiednie składniki odżywcze, by mogły optymalnie spełniać swoje funk-
cje. Odżywianie ma więc fundamentalne znaczenie dla naszej witalności i dobrego samopoczucia. Obok tlenu, wody i tak zwanych makroskładników: białek, węglowodanów i tłuszczów, to przede wszystkim komórkowe składniki odżywcze napędzają procesy życiowe komórek.
Większość komórkowych składników odżywczych jest odpowiedzialna za przyspieszanie tysięcy reakcji biochemicznych w metabolizmie każdej komórki lub w ogóle za ich umożliwienie. Ale struktura, ochrona, zaopatrzenie w energię i funkcjonowanie naszych komórek i narządów – a ostatecznie naszego ciała – są także bezpośrednio związane z komórkowymi składnikami odżywczymi.
Zdrowie jest określane na poziomie komórkowym
04 © Dr. Rath Health Programs B.V.
Organizm Organy Komórki
Erytrocyty
Płytki
RODZAJE KOMÓREK
© Dr. Rath Health Programs B.V. 05
Komórki wątroby
Komórki nerwowe
Komórki mięśni
Komórki krwi
Komórki tkanki łącznej
Komórki ścian naczyń krwionośnych
Limfocyty
NAUKOWO PRZETESTOWANE PRODUKTY ZDROWOTNE
Zdrowa i zbilansowana dieta bogata w świeże ekologiczne owoce i warzywa stanowi podstawę zaopatrzenia naszego organizmu w składniki odżywcze. Nasze produkty uzupełniają te składniki odżywcze istotnymi witaminami, minerałami, pierwiastkami śladowymi i szeregiem innych prozdrowotnych składników. Wspierają one cały metabolizm komórkowy i stanowią cenny wkład w odżywianie w każdym wieku.
Wybierając nasze produkty dokonałeś słusznego wyboru. Kupujesz preparaty, które różnią się od większości suplementów diety dostępnych na rynku, ponieważ zostały one opracowane na podstawie badań naukowych i sprawdzone pod kątem skuteczności.
Synergiczna formuła mikroskładników odżywczych do codziennej suplementacji. Ten i wiele innych produktów jest dostępnych w naszym sklepie internetowym na www.dr-rath.com. Dostęp do sklepu możliwy jest poprzez kod QR.



06 ©
Health Programs B.V.
Dr. Rath
Dr. Rath Vitacor Plus™
Warunkiem koniecznym do tego, aby móc zaoferować Ci produkty najwyższej jakości i o udowodnionych korzyściach jest ścisła współpraca z Instytutem Badawczym dr Ratha, światowym liderem w opartych na naukowych podstawach naturalnych metod leczenia.
Większość firm działających w branży suplementów diety nie prowadzi własnych badań medycznych ani klinicznych. Firmy te polegają raczej na publikacjach osób trzecich – w tym naszych – w celu potwierdzenia rzekomej skuteczności ich produktów.
Zeskanuj kod QR i zapoznaj się z badaniami, zebranymi na stronie:

www.drrathresearch.org
Dr A. Niedźwiecki, od ponad

20 lat kieruje Instytutem dr
Ratha i należy do światowej
czołówki naukowców zajmujących się badaniami nad mikroelementami.
© Dr. Rath Health Programs B.V. 07
Instytut Badawczy dr Ratha jest pionierem w badaniach nad zdrowiem naturalnym. Jako pierwsi poddaliśmy też nasze suplementy diety szczegółowym badaniom na poziomie komórkowym i całego organizmu. Wyniki ponad 10 lat wewnętrznych badań zespołu naukowego skupionego wokół dr Ratha i dr Niedźwiecki zostały opublikowane w wielu niezależnych czasopismach naukowych.
Od ponad dekady nasi naukowcy badają skuteczność, bezpieczeństwo i korzyści płynące z synergii mikroelementów w naturalnej kontroli różnych procesów chorobowych. Naszym celem jest, aby oparte na naukowych podstawach naturalne metody leczenia stały się istotną częścią zorientowanego na pacjenta systemu opieki zdrowotnej we wszystkich krajach świata.
Nasza firma i Instytut dr Ratha są częścią fundacji non-profit, dlatego kupując nasze produkty nie tylko wspierasz swoje zdrowie, ale również pomagasz


kontynuować trwające już od trzech dekad badania nad zdrowiem naturalnym.

08 © Dr. Rath Health Programs B.V.



©
Health Programs B.V. 0 9
Dr. Rath
Instytut dr Ratha na zdjęciach
NATURALNIE OPATENTOWANE: NASZE FORMUŁY
Urząd patentowy USA oficjalnie uznał skuteczność naszych naukowo opracowanych programów mikroelementów. Jak dotąd jesteśmy pierwszą i jedyną organizacją na świecie, która systematycznie patentuje swoje osiągnięcia w dziedzinie badań nad mikroelementami, potwierdzając w ten sposób ich naukowe podstawy. Konsekwencje tej strategii są dalekosiężne: na całym świecie po raz pierwszy moż-
na zapobiegać powszechnym i poważnym problemom zdrowotnym w sposób naturalny, bezpieczny i skuteczny. W dłuższej perspektywie doprowadzi to do zmniejszenia chorób i ich obecnej częstotliwości występowania.
DOWIEDZ SIĘ
WIĘCEJ O NASZYCH
OPATENTOWANYCH
FORMUŁACH:
Relavit™

Opatentowana technologia dla naturalnego rozluźnienia ścian naczyń krwionośnych
Nr artykułu. 0005
YouCell™-V

Opatentowana technologia, która pomaga naturalnie zapobiegać zakażeniom koronawirusami
Nr artykułu. 048
Diacor™







opatentowana technologia pomagająca naturalnie normalizować wysoki poziom cukru we krwi i stymulować produkcję insuliny Nr artykułu. 0007
Lensivit™

opatentowana technologia zdrowotna wspierająca naturalnie prawidłowe funkcjonowanie oczu i chroniąca przed uszkodzeniem oksydacyjnym
Nr artykułu. 047
EpiQuercican™

Opatentowana technologia, która pomaga naturalnie hamować
wzrost komórek nowotworowych
Nr artykułu. 019
10 © Dr. Rath Health Programs B.V.
Efekty biologiczne zestawów mikroelementów, które badaliśmy i testowaliśmy, zostały opatentowane w zakresie nadciśnienia, cukrzycy, nowotworów, raka i zdrowia oczu.

Dla każdego z tych patentów należało udokumentować dużą liczbę badań naukowych, aby udowodnić zarówno specyficzny skład witamin i innych mikroelementów, jak i biologiczną skuteczność tych formuł.
DZIAŁANIE OPATENTOWANYCH
FORMUŁ OBEJMUJE:
• Naturalne rozluźnienie ściany naczyń krwionośnych
• Naturalne obniżenie poziomu cukru we krwi i stymulacja produkcji insuliny
• Naturalne hamowanie dróg zakażeń koronawirusami
• Naturalne hamowanie wzrostu komórek nowotworowych
• Naturalna ochrona funkcji oka przed uszkodzeniem oksydacyjnym

OPATENTOWANE
© Dr. Rath Health Programs B.V. 11
ZNACZENIE SYNERGII MIKROSKŁADNIKÓW ODŻYWCZYCH
Witaminy, minerały, aminokwasy i inne mikroelementy nigdy nie występują w naturze pojedynczo lub w izolacji. W komórkach naszego organizmu są one połączone ze sobą jak w sieci, przy czym optymalna skuteczność pojedynczego mikroelementu w tej sieci zależy od obecności innych mikroskładników odżywczych. Tylko w takim połączeniu substancje te mogą rozwinąć swoją pełną skuteczność.

Wzajemne korzystne efekty, jakie substancje wywierają na siebie, nie tylko zwiększają ich własne korzyści. Pozwalają też innym składnikom odżywczym na lepsze wchłanianie i wykorzystanie przez nasz metabolizm.
Stosując zasadę synergii, osiągamy maksymalny efekt z naszymi produktami bez konieczności uciekania się do bardzo wysokich dawek pojedynczego składnika odżywczego.
Chcesz dowiedzieć się więcej na ten temat? Zapytaj o naszą bezpłatną broszurę „Zdrowie komórkowe” (nr art. 6341).
12 © Dr.
Health Programs B.V.
Rath
WITAMINA C, GŁÓWNY SKŁADNIK PRODUKTÓW DR RATHA
Witamina C jest prawdopodobnie najbardziej znaną ze wszystkich witamin – i nie bez powodu: prawie żadna inna witamina nie spełnia tak wielu różnych funkcji w organizmie. Ważną formą witaminy C jest jej buforowana forma.
Powstaje ona, gdy kwas askorbinowy łączy się z minerałem (zwykle wapniem, magnezem lub potasem). Bufo-
rowana witamina C jest łagodniejsza dla żołądka niż czysty kwas askorbinowy, który może powodować rozstrój żołądka u osób wrażliwych. Buforowana witamina C jest też lepiej metabolizowana przez organizm.
Palmitynian askorbylu jest szczególnie skuteczną formą witaminy C. Jest jednak rzadko stosowany w suplementach diety ze względu na cenę. Palmitynian askorbylu jest rozpuszczalny w tłuszczach, dlatego może być wbudowany w błony i inne struktury komórkowe bogate w lipidy i chronić te struktury przed utlenianiem.

© Dr. Rath Health Programs B.V. 13
JAKOŚĆ PROGRAMÓW ZDROWIA KOMÓRKOWEGO
DR RATHA
Nasze Programy zdrowia komórkowego wyróżnia naukowo opracowany skład poszczególnych produktów. Wysoka jakość naszych produktów jest naszym zobowiązaniem wobec Twojego zdrowia.
Nasze produkty są:
• wolne od genetycznie modyfikowanych substancji roślinnych
• wolne od sztucznych barwników i aromatów
• wolne od alergenów takich jak gluten*, laktoza (cukier mleczny) i pszenica
• nie zawierają żelatyny (zamiast niej stosujemy np. hypromelozę otrzymywaną z włókien roślinnych)
• wolne od drożdży i MSG (glutaminianu sodu)
• wolne od kwasów tłuszczowych trans
* Wyjątek: Formuła z błonnikiem Dr. Rath´s Phytobiologicals™ Balance Control
Naturalne pochodzenie składników:
Tam, gdzie to możliwe, używamy składników i dodatków pochodzenia naturalnego, takich jak:
• owoce cytrusowe, papaje, ananasy, pestki winogron, orzechy kokosowe.
• inne rośliny, zwłaszcza kukurydza, soja, buraki cukrowe, zieloną herbatę, wodorosty, nagietek, wyciągi z kory drzew iglastych
• chondroityna i glukozamina (w Arteriforte™)
z naturalnej tkanki chrzęstnej.

14 © Dr.
Health Programs B.V.
Rath
Papaja
WAŻNE WSKAZÓWKI DOTYCZĄCE SKŁADNIKÓW I DODATKÓW
Jeśli chodzi o składniki naszych produktów, to rozróżniamy substancje aktywne i tak zwane dodatki, które służą do komponowania i kształtowania tabletek.
AKTYWNE SKŁADNIKI
Nasze Programy Zdrowia Komórkowego składają się z wielu różnych
pojedynczych substancji, które współpracują ze sobą, aby pomóc w optymalizacji naturalnych funkcji komórek.
Każda pojedyncza substancja przyczynia się do efektu synergii, a naukowe kompozycje składników są indywidualnie dopasowane do każdego produktu.
Witaminy, aminokwasy, minerały, ekstrakty roślinne i inne mikroskładniki są wyszczególnione na etykiecie wraz z zalecaną dzienną dawką. „Aktywne” składniki – oznacza również, że stosujemy wysokiej jakości formy mikroskładników, które charakteryzują się szczególnie dobrym wchłanianiem i szybkim wprowadzeniem do metabolizmu komórkowego. To odróżnia nasze wysokiej jakości produkty od tanich podróbek.
BIODOSTĘPNOŚĆ
Aby umożliwić szybsze wchłanianie i tym samym optymalną biodostępność komórkowych składników
odżywczych dla organizmu, nasze minerały i pierwiastki śladowe są organicznie związane z aminokwasami glicyną lub metioniną. W ten sposób zapobiegamy przeciwstawnemu działaniu poszczególnych mikroskładników odżywczych.
DODATKI
Dodatki to substancje pomocnicze, które są ważne przy produkcji kapsułek – ale nie przyczyniają się bezpośrednio do działania produktu. Dobrym przykładem jest tu aromat cytrynowy w kapsułce Vitacor Plus, który pochodzi z naturalnego, roślinnego źródła. Bardzo dbamy o to, aby całkowicie unikać zbędnych lub wątpliwych dodatków.

© Dr. Rath Health Programs B.V. 15
ZALECENIA DOTYCZĄCE SUPLEMENTACJI
PRZYJMOWANIE
Programy Zdrowia Komórkowego przyjmuj w ciągu dnia z posiłkami i odpowiednią ilością płynu (woda, sok, herbata). Dzięki temu osiąga się stałe stężenie mikroskładników we krwi i równomierne wchłanianie składników przez organizm, jak również ulepszone wchłanianie rozpuszczalnych w tłuszczach witamin E, D i beta-karotenu.
Jeśli przyjmujesz kilka produktów dziennie, to możesz przyjmować je również z przekąskami.

CZAS SUPLEMENTACJI

Podstawowe zaopatrzenie organizmu – na przykład dzięki formułom Vitacor Plus™ & Dr. Rath’s Phytobiologicals™ – powinno odbywać się regularnie. Tak długo jak żyjemy, miliony komórek zużywają energię komórkową, którą musimy dostarczyć do naszego organizmu.
Więcej informacji znajdziesz w naszym bezpłatnym katalogu produktów „Programy Zdrowia Komórkowego dr Ratha” (nr art. 20991).

16 © Dr. Rath Health Programs B.V.
ŻYWNOŚĆ – ODPOWIEDNIE ŹRÓDŁO KOMÓRKOWYCH SKŁADNIKÓW ODŻYWCZYCH?
Naturalne produkty, takie jak owoce i warzywa, rosną głównie w monokulturach, co oznacza, że tylko jeden rodzaj roślin rośnie na całym polu. W rezultacie plony są wyższe, a rolnik zarabia więcej.
Monokultury mają jednak tę wadę, że gleba zostaje wyjałowiona ze względu na specyficzne wymagania odżywcze rośliny i konieczne jest stosowanie nawozów, aby pobudzić roślinę do wzrostu. Zaprzecza to naturalnej regeneracji gleby, a rosnąca na niej roślina jest uboższa w ważne składniki odżywcze, może nie być w stanie wytworzyć substancji obronnych, aby chronić się
przed szkodnikami i innymi czynnikami. W związku z tym konieczne jest stosowanie środków ochrony roślin.
Kolejnym problemem jest przedwczesny zbiór owoców, aby przetrwały tysiące kilometrów transportu. Naukowcy odkryli, że w ostatniej fazie dojrzewania owocu wytwarzana jest większość niezbędnych substancji ochronnych. Jeśli roślina zostanie pozbawiona tego ważnego okresu dojrzewania, to nie będzie w stanie dostarczyć nam niezbędnych dla życia komórkowych składników odżywczych.
© Dr. Rath Health Programs B.V. 17
Zmniejszenie zawartości mikroelementów w marchwi i fasoli Wapń -24% Magnez -75% Wapń -51% Magnez -31% Straty 1985-2002
ZADANIA I CELE NASZEJ PRACY
Działamy pod patronatem Fundacji Zdrowia dr Ratha. Oznacza to, że wszystkie wygenerowane zyski są przeznaczane na dalsze badania i edukację zdrowotną. Podstawą naszej pracy jest badanie mikroskładników odżywczych i ich znaczenia dla zdrowia. Upowszechnienie tej wiedzy powinno utorować drogę dla nowego systemu opieki zdrowotnej opartego na skutecznych, pozbawionych skutków ubocznych i niedrogich naturalnych metodach leczenia.
Nadrzędnym celem naszej pracy jest strategia zdrowotna ukierunkowana na profilaktykę. Silny system odpornościowy to tylko jeden z przykładów, dla których oferujemy naturalne i skuteczne rozwiązania. Przywrócenie i utrzymanie zdrowia milionów ludzi na całym świecie jest bliskie naszemu sercu. Oczywiście w naturalny sposób!
Nasze cele:
• Edukacja zdrowotna
• Promowanie naukowo uzasadnionych naturalnych metod leczenia

• Badania i rozwój nowoczesnych suplementów diety
• Stworzenie nowoczesnego, opartego na profilaktyce systemu opieki zdrowotnej
18 © Dr. Rath Health Programs B.V.

Health Programs B.V. 19
© Dr. Rath
PROJEKT OGRÓDKÓW SZKOLNYCH W AFRYCE
Zwrot w kierunku prewencji zdrowia nie może ograniczać się jedynie do kilku bogatych krajów uprzemysłowionych. Dlatego właśnie uruchomiliśmy w Afryce projekt „Movement of Life”.
W projekcie ogródków szkolnych „Movement of Life” dzieci i młodzież uczą się o korzyściach zdrowotnych płynących z uprawy warzyw i owoców w domu, planują i pielęgnują szkolny ogródek, zachęcają do zakładania ogródków w miejscach, w których mieszkają ich rodziny, a także przyczyniają się do poprawy zdrowia w całym regionie.
Sukces naszej inicjatywy można wyrazić w liczbach: We wschodnioafrykańskiej Ugandzie, która jest jednym z najbiedniejszych krajów na świecie, od rozpoczęcia projektu w 2015 r. posadzono ponad 12 tyś drzew owocowych. Obecnie, już ponad 100 tyś osób w Ugandzie korzysta z tego projektu (Status: lipiec 2020).

A więc kupując nasze produkty wspierasz projekt „Movement of Life” Fundacji Zdrowia dr Ratha w Afryce i przyczyniasz się do poprawy jakości życia żyjących tam ludzi.
Zdrowie dla wszystkich oznacza jednocześnie edukację dla wszystkich.
20 © Dr. Rath Health Programs B.V.
Foto: arnaldo-aldana-HfH5yd70ox8-unsplash


Więcej informacji na temat tego i innych projektów „Movement of Life” oraz pracy Fundacji Zdrowia dr Ratha można znaleźć na stronie www.movement-of-life.org . Zeskanuj ten kod QR. © Dr. Rath Health Programs B.V. 21
Właśnie poznałeś naszą firmę i dowiedziałeś się, co sprawia, że Programy Zdrowia Komórkowego dr Ratha są tak wyjątkowe i wartościowe. Dowiedziałeś się o naukowcach stojących za badaniami mikroskładników odżywczych i opracowywaniem formuł produktów. Dowiedziałeś się również o znaczeniu synergii mikroelementów i ich pozytywnym wpływie na komórki organizmu. Mogłeś przekonać się o wysokich standardach, jakie stawiamy jakości naszych wyjątkowych produktów. Poznałeś pracę naszej fundacji i założenie „Zdrowie dla wszystkich” na przykładzie projektu „Movement of Life”.
ABONAMENT KOMÓRKOWYCH SKŁADNIKÓW ODŻYWCZYCH
Jeśli już od jakiegoś czasu przyjmujesz nasze produkty i przekonałeś się o ich wartości dla Twojego zdrowia, to polecamy Ci abonament Programów Zdrowia Komórkowego.
Wybierz swoje wybrane produkty, resztą zajmiemy się my. Co dwa miesiące będziemy automatycznie wysyć Twoje wybrane produkty. Automatycznie będziesz otrzymywał wybrane produkty bez kosztów transportu. Dzięki temu już nigdy nie zabraknie Ci Twoich ulubionych suplementów. A gdyby i to nie było jeszcze wystarczającym powodem do założenia abonamentu to na pewno przekona Cię 12-sty miesiąc za darmo*.
Zalety zamówienia abonamentowego
• Bezpłatne produkty w 12-tym miesiącu
• Brak kosztów transportu
• Brak dodatkowych kosztów
• Nigdy więcej nie zapomnisz o zamówieniu

22 ©
Dr. Rath Health Programs B.V.
Mójjużabonament jest!
 * W abonamencie, z 2 miesięcznym odstępem dostaw, za 6 paczkę zapłacisz jedynie połowę (warunkiem jest brak zmian w asortymencie abonamentu w przeciągu roku). Uwaga: Zamówienie abonamentowe nie kończy się automatycznie po upływie roku. Wypowiedzenia abonamentu należy dokonać, co najmniej, 14 dni przed planowaną datą kolejnej dostawy. Założenie nowego abonamentu jest możliwe dopiero po 3 miesiącach od daty wypowiedzenia pierwszego.
* W abonamencie, z 2 miesięcznym odstępem dostaw, za 6 paczkę zapłacisz jedynie połowę (warunkiem jest brak zmian w asortymencie abonamentu w przeciągu roku). Uwaga: Zamówienie abonamentowe nie kończy się automatycznie po upływie roku. Wypowiedzenia abonamentu należy dokonać, co najmniej, 14 dni przed planowaną datą kolejnej dostawy. Założenie nowego abonamentu jest możliwe dopiero po 3 miesiącach od daty wypowiedzenia pierwszego.
PROGRAM AFILIACYJNY


Jesteś już przekonany do naszych naukowo przetestowanych produktów i chciałbyś podzielić się swoimi doświadczeniami z innymi ludźmi? W takim razie zapraszamy cię do naszego programu afiliacyjnego. Twoje zaangażowanie zostanie nagrodzone, bez obowiązku składania comiesięcznych zamówień czy minimalnej sprzedaży. Po prostu zarejestruj się i zacznij działać: podziel się zdobytą wiedzą lub opowiedz innym o swoich doświadczeniach z naszymi produktami.
Na naszej stronie znajdziesz film objaśniający oraz dalsze informacje, np. na temat ofert edukacyjnych. Link do strony dostępny jest pod kodem QR:

24 © Dr. Rath Health Programs B.V.
WIĘCEJ PYTAŃ? ?
Zadzwoń do nas, jeśli masz jeszcze jakieś pytania. Z zespołem naszych konsultantów możesz się skontaktować od poniedziałku do piątku w godzinach od 08:30 do 17:00.
Bezpłatny Serwis Klienta i Zamówienia*:
00800 – 11 24 639
Mamy nadzieję, że wzbudziliśmy Twoje zainteresowanie naszymi Programami

Zdrowia Komórkowego oraz naszą działalnością, i że jesteś zadowolony z naszych produktów.
Zespół
Dr. Rath Health Programs
Health Programs B.V. 25
© Dr. Rath
* nr bezpłatny dla dzwoniących z telefonu stacjonarnego. Dla dzwoniących z telefonu komórkowego, opłata zgodna z taryfą operatora.
Dr. Rath Health Programs B.V.


Postbus 657 | 6400 AR Heerlen | Holandia
Fax: 0031 - 457 111 119


info@rath-programs.com www.dr-rath.com

#1862/02-280323/PL/

* W abonamencie, z 2 miesięcznym odstępem dostaw, za 6 paczkę zapłacisz jedynie połowę (warunkiem jest brak zmian w asortymencie abonamentu w przeciągu roku). Uwaga: Zamówienie abonamentowe nie kończy się automatycznie po upływie roku. Wypowiedzenia abonamentu należy dokonać, co najmniej, 14 dni przed planowaną datą kolejnej dostawy. Założenie nowego abonamentu jest możliwe dopiero po 3 miesiącach od daty wypowiedzenia pierwszego.
* W abonamencie, z 2 miesięcznym odstępem dostaw, za 6 paczkę zapłacisz jedynie połowę (warunkiem jest brak zmian w asortymencie abonamentu w przeciągu roku). Uwaga: Zamówienie abonamentowe nie kończy się automatycznie po upływie roku. Wypowiedzenia abonamentu należy dokonać, co najmniej, 14 dni przed planowaną datą kolejnej dostawy. Założenie nowego abonamentu jest możliwe dopiero po 3 miesiącach od daty wypowiedzenia pierwszego.




